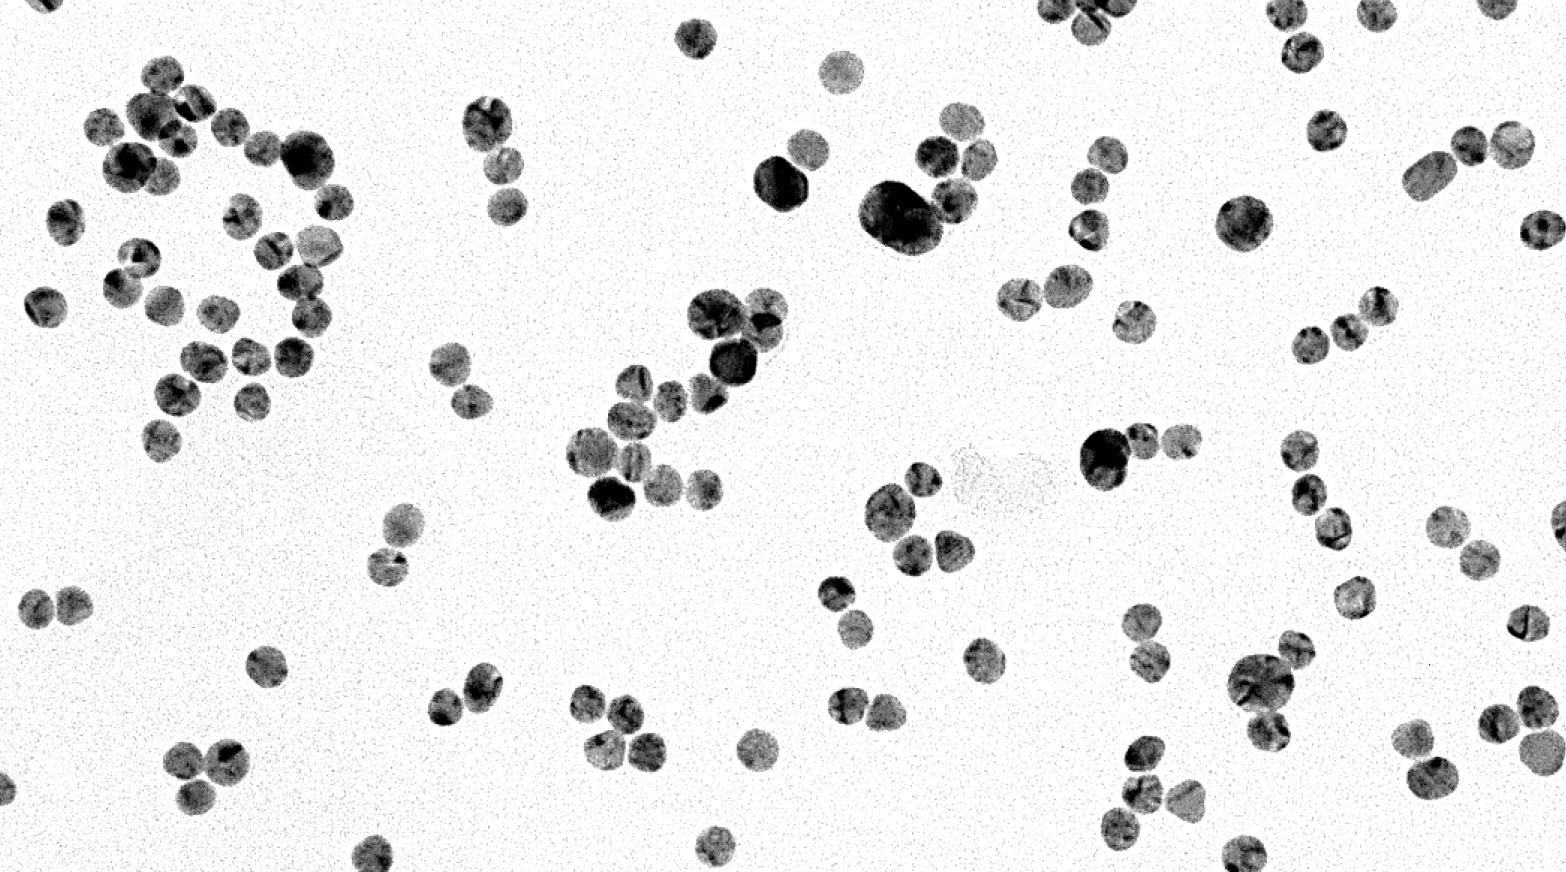

News
- July 27th, 2020: Kick-off meeting
of the Spanish network
MultiMetDrugs.
- Jordi Grau, Amparo Caubet and Patrick Gamez publish a paper in ChemBioChem on cytotoxic copper(II) complexes. see the Cover Picture here
Important Conferences
June 15-18, 2025
- Uppsala - Sweden
17th International Symposium on Applied Bioinorganic Chemistry
June 28-July 3, 2026 - Odense - Denmark
ICCCs represent the largest venue for the exchange of the latest knowledge in the field of coordination chemistry and related areas among researchers from all over the world.